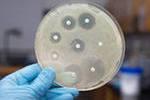
Американские ученые создали препарат, к  которому микробы не могут приспособиться

Архив новостей 15 ноября 2013 г.

egyptian-pharaohs.net – лучший ресурс для всех, кого интересуют боги древних египтян
Многие ученые всего мира веками занимались и продолжают заниматься на сегодняшний день вопросами раскрытия тайн возникновения мира, человеческог...

Владимир Владимиров встретился с руководителями бизнес-объединений Ставрополья
Временно исполняющий обязанности губернатора Владимир Владимиров встретился с руководителями бизнес-объединений Ставропольского края...

На Ставрополье борца с экономическими преступлениями осудили за покушение на получение взятки
Промышленный районный суд Ставрополя вынес приговор по уголовному делу в отношении бывшего старшего оперуполномоченного отдела по борьбе с налоговыми...

В Ставрополе затянулись работы по реконструкции улицы Космонавтов
В Ставрополе на неопределенное время затягиваются работы по реконструкции автомобильной дороги улицы Космонавтов. Напомним, участок дороги от кордона...

В Ставрополе прошел форум, посвященный Дню памяти жертв ДТП
На днях в Ставрополе под девизом «Безопасность на дорогах - цель, объединяющая нас!» прошел форум, посвященный Дню памяти жертв ДТП, сообщает пресс-сл...

На Ставрополье с рабочим визитом побывал зампред ЦИК России Леонид Ивлев
На Ставрополье с рабочим визитом прибыл заместитель председателя Центральной избирательной комиссии России Леонид Ивлев. Он принял участие в семинаре-...

Кальций круглый год
Кальций на все сезоны Немного биохимии: среди всех элементов, входящих в состав тела человека, кальций находится на пятом месте после четырех глав...

Одаренные школьники Ставрополья приняли участие в форуме «Будущие интеллектуальные лидеры России»
Одаренные школьники Ставрополья приняли участие в первом Всероссийском форуме «Будущие интеллектуальные лидеры России». Форум, состоявшийся в Ярослав...

Краевые парламентарии: На здоровье жителей Ставрополья экономить нельзя
По инициативе комитета по социальной политике депутаты Думы Ставропольского края провели рейд в Минераловодском районе. Его целью стал контроль за рас...

Более 20 семейных животноводческих ферм на Ставрополье получили деньги от государства
На Ставрополье около трех миллионов рублей на развитие собственных хозяйств получила 21 семейная животноводческая ферма. Все они - победители конкурса...

На Ставрополье ссора между двумя мужчинами закончилась пулевым ранением
В Изобильном на одной из улиц города произошла ссора между 29-летним местным жителем и приезжим из хутора Широбокова. Конфликт закончился тем, что гор...

В центре Ставрополя загорелся пассажирский автобус
В пятницу около часа дня в Ставрополе, на пересечении улиц Морозова и Льва Толстого произошло возгорание пасажирского автобуса, выполняющего рейс по м...

mebel-komfort.su - мебель из мдф в Краснодаре
На сегодняшний день трудно представить себе квартиру или рабочее помещение без соответствующей мебели, которая дает нам возможность чувствовать себя у...

На Ставрополье учредителей кооператива подозревают в мошенничестве на 82 миллиона рублей
В прокуратуре края состоялось межведомственное совещание по уголовному делу о мошенничестве, связанном с обманом вкладчиков КПКГ «Возрождение-плюс»...

Минфин: На финансирование дефицита краевого бюджета удалось взять выгодный заём
14 ноября были подведены итоги открытых аукционов в электронной форме на оказание услуг по предоставлению денежных средств в форме открытия возобновля...

promtehmash.com – лучший ресурс для всех, кого интересует кассета к фжу
Одной из постоянно развивающихся отраслей народного хозяйства является нефтяная промышленность. Для создания оптимальных условий работы в нефтех...

В Железноводске судебного пристава заподозрили в получении взятки
13 ноября в следственный отдел по Пятигорску краевого СУ СКР поступили материалы оперативно-розыскной деятельности о получении судебным приставом-испо...

Глава администрации Ставрополя дал высокую оценку результативности акции «Овощи к подъезду»
Акция по сезонной торговле плодоовощной продукцией в краевом центре «Овощи к подъезду» находится в завершающей стадии. Руководитель комитета муниципал...

Житель Ставрополья получил серьезные травмы головы во время ремонта лущильника
В Алесандровском районе проводится доследственная проверка по факту получения мужчиной травмы при проведении сельскохозяйственных работ...

Глава Ставрополья Владимир Владимиров поздравил участковых полиции
17 ноября службе участковых уполномоченных полиции исполняется 90 лет. В прошедшем в Ставрополе торжественном собрании, приуроченном к праздничной дат...

bezopasnosti.ru - пожарная сигнализация
Практически в каждой отрасли народного хозяйства не обойтись без установки различных систем безопасности, включая видеонаблюдение, разные виды с...

Педофила из Степновского района приговорили к 20 годам тюрьмы
Житель села Соломенского Степновского района 1970 года рождения Александр Балабукочкин признан виновным в изнасиловании, в шести эпизодах насильственн...

pioneer-carsound.ru - автомагнитолы с навигацией
Кто из нас сегодня не любит послушать приятную музыку, она сопровождает нас повсюду: на улице и дома, на работе и по пути домой… Где бы мы ни бы...

Торгово-промышленную палату Ставропольского края возглавил Борис Оболенец
14 ноября состоялась конференция Торгово-промышленной палаты Ставропольского края. Основным вопросом повестки дня стало избрание нового президента ТПП...

Аромат счастья
Ароматерапевты большое значение придают запахам, наделяют их огромнейшей силой. Аромат может успокоить, вдохновить, придать силы, пробудить воспоминан...

Пять продуктов против простуды
Каждый человек, который хоть раз болел гриппом, знает, что для того чтобы процесс выздоровления проходил быстрей необходимо не только принимать лекарс...

Глава Ставрополья совершил рабочую поездку в Минераловодский район
Временно исполняющий обязанности губернатора Ставрополья Владимир Владимиров накануне совершил рабочую поездку в Минераловодский район, сообщила пресс...

В инфарктах тоже виноваты гены
Ученые Немецкого кардиологического центра в Мюнхене и Лестерского университета в Великобритании обнаружили ген, который повышает риск возникновения и...
Американские ученые создали препарат, к которому микробы не могут приспособиться
В последнее время стало очень сложно лечить инфекционные заболевания, потому что бактерии легко приспосабливаются к антибиотикам...

Лопес вернулась к 26-летнему любовнику
Дженнифер Лопес простила танцовщик Каспера Смарта, своего молодого любовника. Пару увидели вместе во время того, как они выходили из итальянского рес...